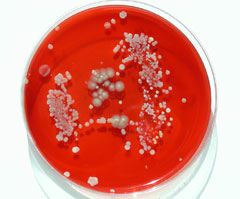
����� �����

За достижения, которые сначала вызывают смех, а затем – раздумья
 Карл Крушельницкий (Karl Kruszelnicki) чашка Петри | Автомобиль Алкоголь Вера
Война Волосы Врачи
Геометрия Дети Женщины
Животные Запах Звук
Здоровье Кино Кладбище
Книга Космос Кофе Кошка
Лицо Мозг Мужчины
Музей Музыка Насекомые Общество Пенис
Предметы Продукты Психология
Птицы Разное Растения Секс Собака
Спорт Суд Техника Туалет
Финансы Цвет Экскременты /Реклама/ За пределами науки. Загрязняет ли операционную медсестра тихо пукая?решено было пустить газы прямо в две чашки Петри с расстояния пять сантиметров Британский медицинский журнал (British Medical Journal), 323, 22–29, декабрь 2001. Перепечатано из Canberra Times, 17 июля 2001, автор: Майкл Дойл. Предоставлено Саймоном Чепменом, кафедра общественного здравоохранения и общественной медицины, Сиднейский университет. Введение Все началось с вопроса медсестры, — рассказал доктор Карл Крушельницкий (Karl Kruszelnicki) слушателям своей научной программы на радиостанции Triple J в Брисбене. Она хотела узнать, не загрязняет ли операционную, в которой работала, тихо пукая в стерильной среде во время операций. И я понял, что не знаю, загрязняет она операционную, тихо пукая, или не загрязняет. Но я твердо решил незамедлительно выяснить этот вопрос. Далее описан метод, с помощью которого установлено, являются ли человеческие газы зараженными микробами или просто имеют неприятный запах. Приглашен Люк Теннентм (Luke Tennent), микробиолог из Канберры, и они вместе разработали методику эксперимента. Эксперимент Решено пустить газы прямо в две чашки Петри с расстояния 5 сантиметров. Сначала в одежде (в одну чашку), затем со спущенными штанами (в другую). Карл Крушельницкий внимательно наблюдал за происходящим и давал, при необходимости, профессиональные советы. За ночь во второй чашке Петри появились видимые комки мягких бактерий, которые обычно обнаруживаются только в кишечнике и на коже. Но газы, прошедшие через одежду, в первой чашке, не вызвали размножения бактерий. Это говорит о том, что одежда действует на газы как фильтр. Специалисты пришли к выводу, что зона кишечных бактерий во второй чашке Петри вызвана самими газами, а разбрызгивание вокруг неё вызвано высокой скоростью газов, которые перенесли бактерии из места их происхождения прямо на чашку. Поэтому, стало ясно, по-видимому, что газы могут вызывать инфекцию, если человек, выпускающий газы, голый. Но если он (или она) одеты, то нет. При этом результаты эксперимента не следует считать тревожными, поскольку ни один из типов полученных бактерий не вреден. На самом деле, они очень похожи на «полезные» бактерии, содержащиеся в йогурте. Окончательный вывод Не пукайте голыми рядом с едой. Это, конечно, не высшая математика. Но, с другой стороны, может быть, это все-таки высшая математика? Как посмотреть. Специалисты готовы провести длительное расследование, если удастся найти желающего корпоративного спонсора. Предлагается серию тестов, включающих пукание на агарные тарелки с разных расстояний (от 5 до 30 см) после употребления определённых продуктов и напитков. Кроме того, возможно использование пикфлометра для проверки силы и того, как это соответствует результатам посева. Доктор Карл Крушельницкий — учёный, врач и инженер, чья жизнерадостная личность и талант рассказчика сделали его известным автором и популяризатором науки. Помимо степеней в области физики и математики, биомедицинской инженерии и медицины, он несколько лет учился в различных университетах по специальностям астрофизика, информатика и философия. Работал физиком, разнорабочим, техником у музыкальных групп, автомехаником, кинорежиссёром, биомедицинским инженером (когда он разработал и построил устройство для улавливания электрических сигналов с сетчатки глаза человека), телеведущим прогнозов погоды, научным репортёром и врачом в Детской больнице Сиднея. Доктор Карл за свою карьеру получил несколько престижных и уникальных наград. В 2002 году удостоен престижной Игнобелевской премии, присуждаемой Гарвардским университетом в США, за новаторское исследование пупочного ворса и причин его почти всегда синего цвета. В 2003 году удостоен высокой чести быть названным «Отцом года Австралии». В 2006 году он также получил награду «Член Ордена Австралии». В 2007 году Австралийское общество скептиков наградило его премией «Скептик года Австралии». В 2012 году астероид 18412 назван в его честь. Астероид Dr Karl/18412 обнаружен Робертом Х. Макнотом в обсерватории Сидинг-Спринг в Кунабарабране, Новый Южный Уэльс, Австралия, 13 июня 1993 года. В 2012 году назван Национальным живым сокровищем Национальным фондом Австралии (Новый Южный Уэльс). В 2016 году доктор Карл получил почетную докторскую степень от Университета Саншайн-Кост. В 2019 году Организация Объединенных Наций наградила доктора Карла премией ЮНЕСКО «Калинга» за популяризацию науки. В 2024 году доктор Карл получил почетную докторскую степень от Университета Ньюкасла и грант на резиденцию в Центре Белладжо от Фонда Рокфеллера для разработки стратегии использования ИИ для противодействия дезинформации об изменении климата. В СМИ Карл был автором и ведущим первого сезона программы «Квант» и с тех пор является научным комментатором на телевидении. На радио он выступает в эфире около 5 часов каждую неделю. Это включает в себя еженедельное общенациональное часовое научно-популярное ток-шоу на радио Triple J, которое только в пяти столицах привлекает более 750 000 слушателей, а количество загрузок подкаста превышает 6 миллионов. Он выпускает еженедельный подкаст Сиднейского университета «Shirtloads of Science», в котором коллеги-ученые рассказывают о своих последних исследованиях. Доктор Карл является покровителем премии Sleek Geeks Eureka Schools Prize Сиднейского университета, которая поощряет учащихся излагать научные концепции доступным и увлекательным способом. Она призвана поддерживать начинающих молодых ученых по всей стране, которые станут нашими будущими лидерами в исследованиях, открытиях и коммуникации. Карл дважды в неделю проводит бесплатные онлайн-сессии вопросов и ответов по науке для школьников. Карл написал 48 книг, и еще больше находится в процессе. Его хобби включают путешествия по австралийской глубинке, семейный отдых, фитнес, музыку, много танцев и написание статей для журналов о внедорожниках. 12.12.2025 Комментарий:
Источник - пресса |
| (c) 2010-2026 Шнобелевская премия | ig-nobel@mail.ru |

